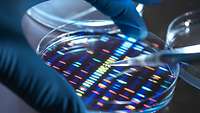
Eine Hand tropft aus einer Pipette auf eine Petrischale

Durch die standardisierte Aufbereitung der Daten können Unternehmen diese leichter nutzen
© Westend61 / Getty Images
Durch die standardisierte Aufbereitung der Daten können Unternehmen diese leichter nutzen
© Westend61 / Getty Images
Die Digitalstrategie der Bundesregierung sieht vor, in allen Bundesministerien Datenlabore zu etablieren. Der Grundstein für die Datenlabore wurde bereits in der vergangenen Legislaturperiode im Rahmen der Datenstrategie vom Januar 2021 gelegt. Viele dieser Einrichtungen befinden sich derzeit noch in der Aufbauphase. Sie beschäftigen sich mit der Datenanalyse und -aufbereitung und sollen der öffentlichen Verwaltung dabei helfen, datenbasierte Entscheidungen zu treffen und interne Prozesse zu optimieren.
Die Datenlabore haben zum Ziel, die Daten- und Digitalkompetenz in den Ministerien zu erhöhen. Dies erlaubt es den Ministerien, evidenzbasierte Entscheidungen zu treffen und bessere Prognosen aufzustellen. Für Unternehmen ist das von großer Bedeutung, da es ein schnelleres und effektiveres Handeln ermöglicht. So können bestimmte Entwicklungen (zum Beispiel im Bereich Gesundheit oder Energie) frühzeitiger vorausgesagt und antizipiert werden.
Datenlabore können beispielsweise beim Beschluss von Maßnahmen zur Pandemiebekämpfung oder zur Abfederung von anderen wirtschaftlichen Schocks eine wichtige Rolle spielen. Ein Datenlabor könnte zum Beispiel den Verlauf einer Pandemie modellieren und dabei auch die Auswirkungen auf die Unternehmen mitberücksichtigen. Die Verlaufsprognose aus dem statistischen Modell könnte dann zum einen genutzt werden, um den optimalen Zeitpunkt für Maßnahmen zu bestimmen. Zum anderen könnten aber auch deren Effekte auf den weiteren Verlauf geschätzt und somit evaluiert werden, ob sie die Pandemie effektiv bekämpfen. So würden Unternehmen vor stark geschäftseinschränkenden Maßnahmen bewahrt, die wenig dazu beitragen, die Verbreitung der Pandemie zu stoppen.

© DIHK